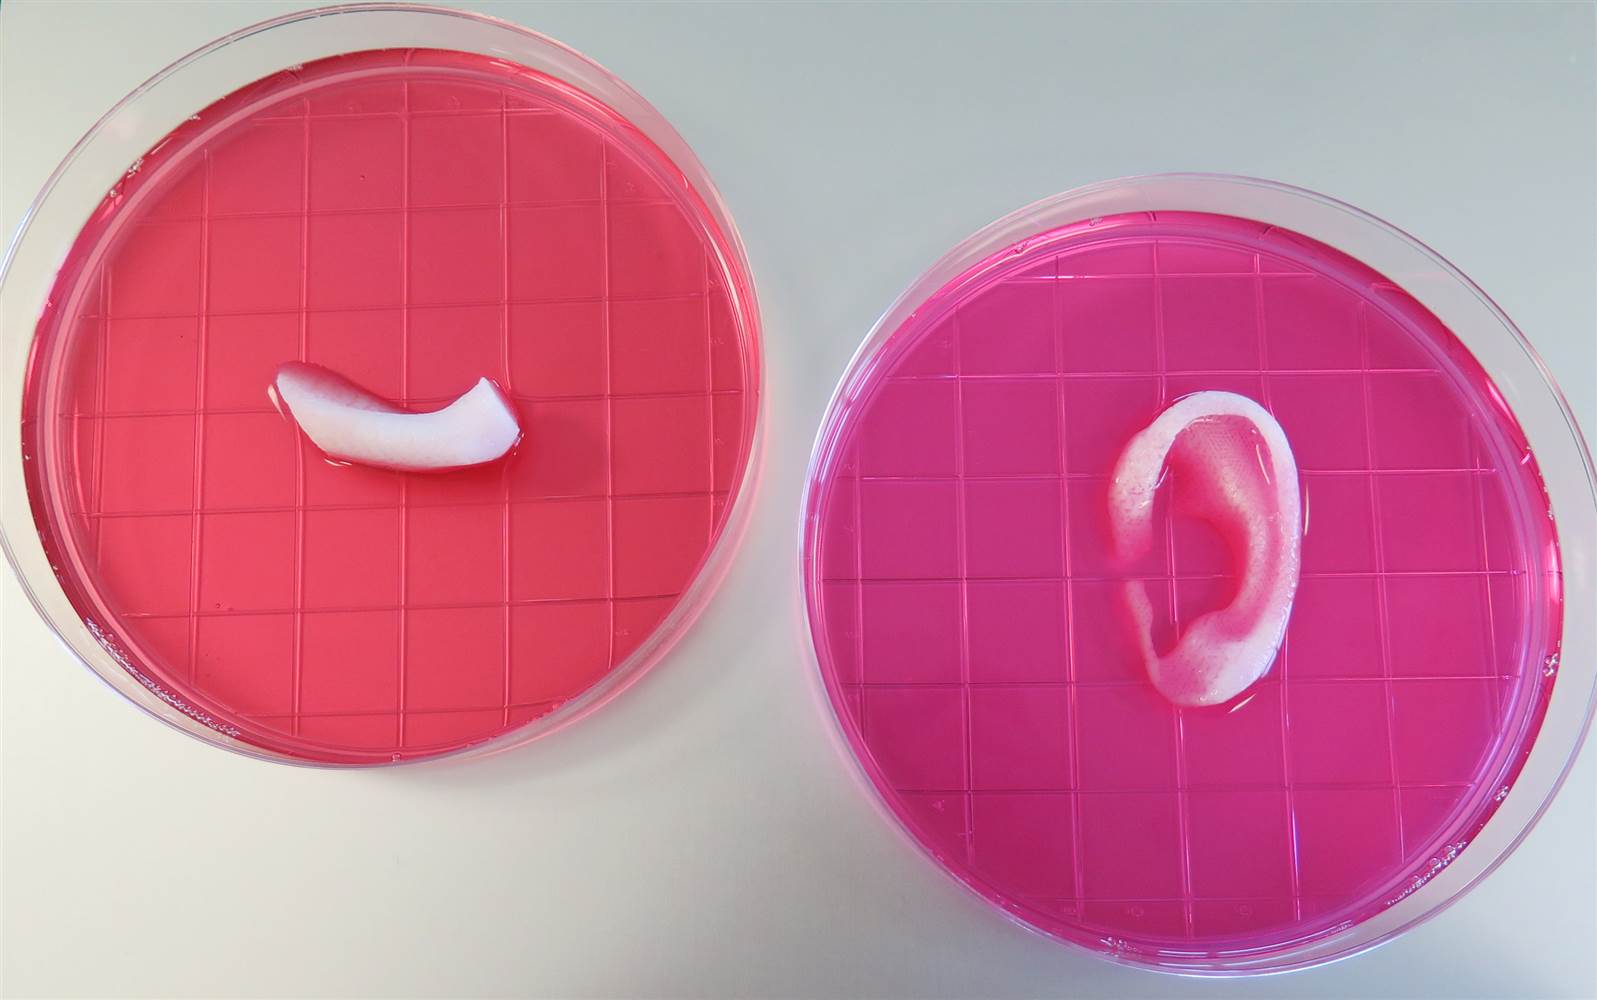
最新的3D生物打印机可以使“活着”的身体部位2

一组科学家设法创建了一个3D生物生产商,该生物生产商能够创建诸如骨骼,肌肉和软骨之类的物品,随后将用于移植。目前已经使用新材料创建耳朵的小组正在测试实验室动物中的技术,并计划在不久的将来对人类进行测试。
该研究结果已在自然生物技术中发表,新机器印刷的器官基本上是“活着”的,以粗略地说。这些结构是多孔的特殊结构,可允许其周围的人类细胞的生长并促进连接。这些材料具有微通道,可作为毛细管床,并使身体的活组织能够周围形状,从而形成新的结构。
维克森林再生医学研究所的安东尼·阿塔拉(Anthony Atala)说:“它可以制造任何形状的稳定的人尺度组织。随着进一步的开发,该技术有可能用于打印生物组织和器官结构以进行手术植入。”
创建的生物模具取决于通过MRI和CT扫描获得的信息。该小组还设法使用此技术创建了下颌部分。塑料使用缓慢地分解,使活细胞留在后面,连接到已经存在的人体组织。这意味着我们可以3D打印身体部位并将其移植,并且它们将成为接收者的功能成员。